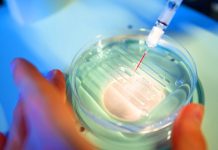
Un paso gigante en la investigación del Síndrome de Down: Científicos japoneses eliminan el cromosoma extra

Estudio de Harvard señala la importancia de las uñas para determinar la longevidad de...
Un nuevo estudio innovador de la Universidad de Harvard, sugiere una sorprendente correlación entre la velocidad de crecimiento de las uñas y la capacidad...
Descubren un nuevo tratamiento para regenerar los dientes perdidos en adultos (+ Detalles)
La nueva medicina regenerativa está demostrando que en el futuro la pérdida de los dientes no tiene por qué ser definitiva. Ya se está...
Organización Mundial de la Salud alerta sobre posible propagación global del virüs del Chikungunya
La Organización Mundial de la Salud (OMS) ha emitido una alerta global debido a la rápida expansión del virüs chikungunya, que se ha propagado...
Según estudio, dormir profundamente podría ayudar a prevenir la enfermedäd de Alzheimer
Un simple hábito diario, a menudo subestimado en la juventud, podría ser una de las claves para prevenir el deterioro cognitivo asociado a la...
Venezolana desarrolló sandalias inteligentes que previenen apuntacïones a personas con dïabetes (+ Detalles)
Odra Velásquez, una enfermera venezolana consiguió desarrollar unas innovadoras sandalias inteligentes diseñadas para monitorear la salud de los pies y prevenir amputacïones en pacientes...
Un estudio realizado reveló los daños irreversibles que provoca la falta de sueño (+...
Dormir no es solo una actividad placentera, sino que se trata de una necesidad biológica que permite que el cuerpo y, sobre todo, el...
Un paso gigante en la investigación del Síndrome de Down: Científicos japoneses eliminan el...
Investigadores de la Universidad de Mie, en Japón, han logrado un hito sin precedentes en la lucha contra el Síndrome de Down. En un...
En Europa proponen primer inhalador para dolenciäs respiratorias con gas propulsor ecológico (+ Detalles)
La Agencia Europea de Medicamentos (EMA) ha recomendado este viernes aprobar la primera reformulación en la Unión Europea (UE) de un fármaco administrado por vía...
Estudio señala que dar 7 mil pasos al día puede ayudar a reducir los...
Un estudio reciente, publicado en The Lancet y llevado a cabo por expertos de la Universidad de Sídney, Australia, con datos de más de...
Pepper, el gato doméstico que ayuda a los científicos a descubrir nuevos vïrus (+...
Un inesperado colaborador de la ciencia, un gato doméstico llamado Pepper, facilita el descubrimiento de una nueva cepa viral en Florida, Estados Unidos. Este...